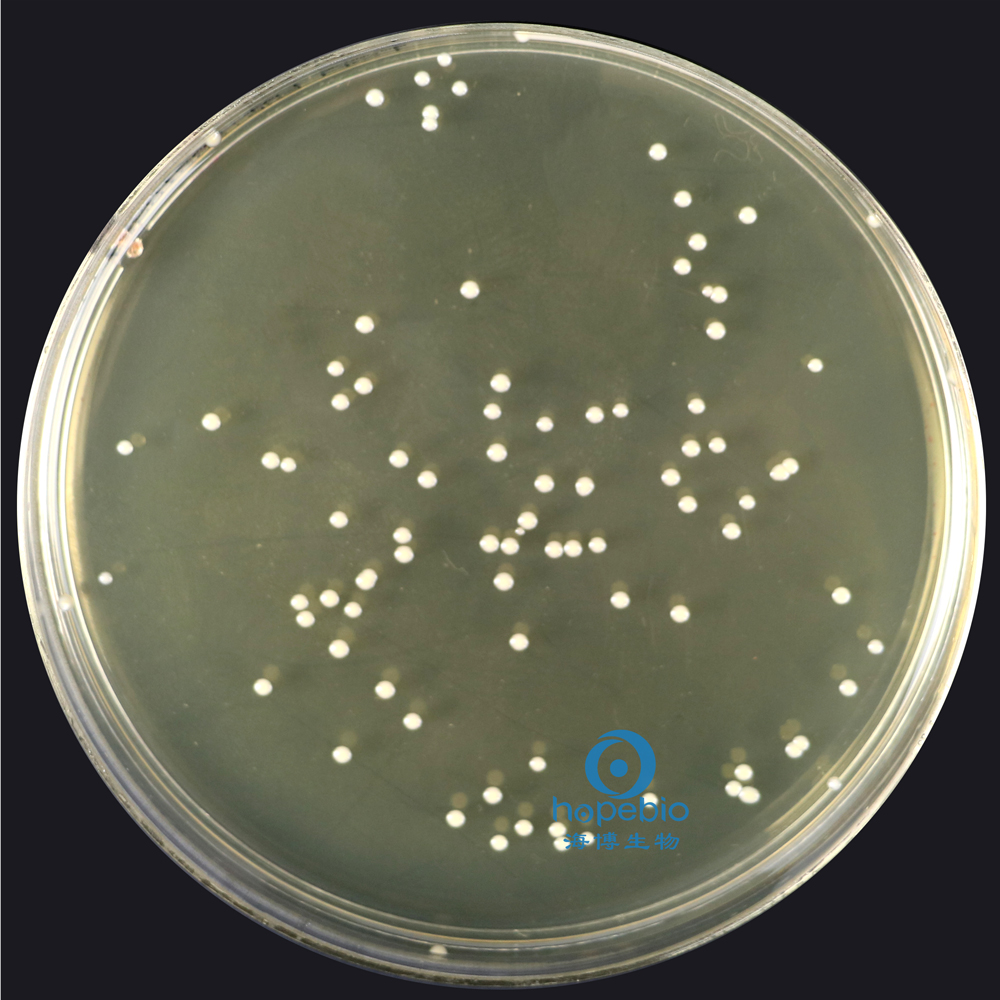
产品细节图片1
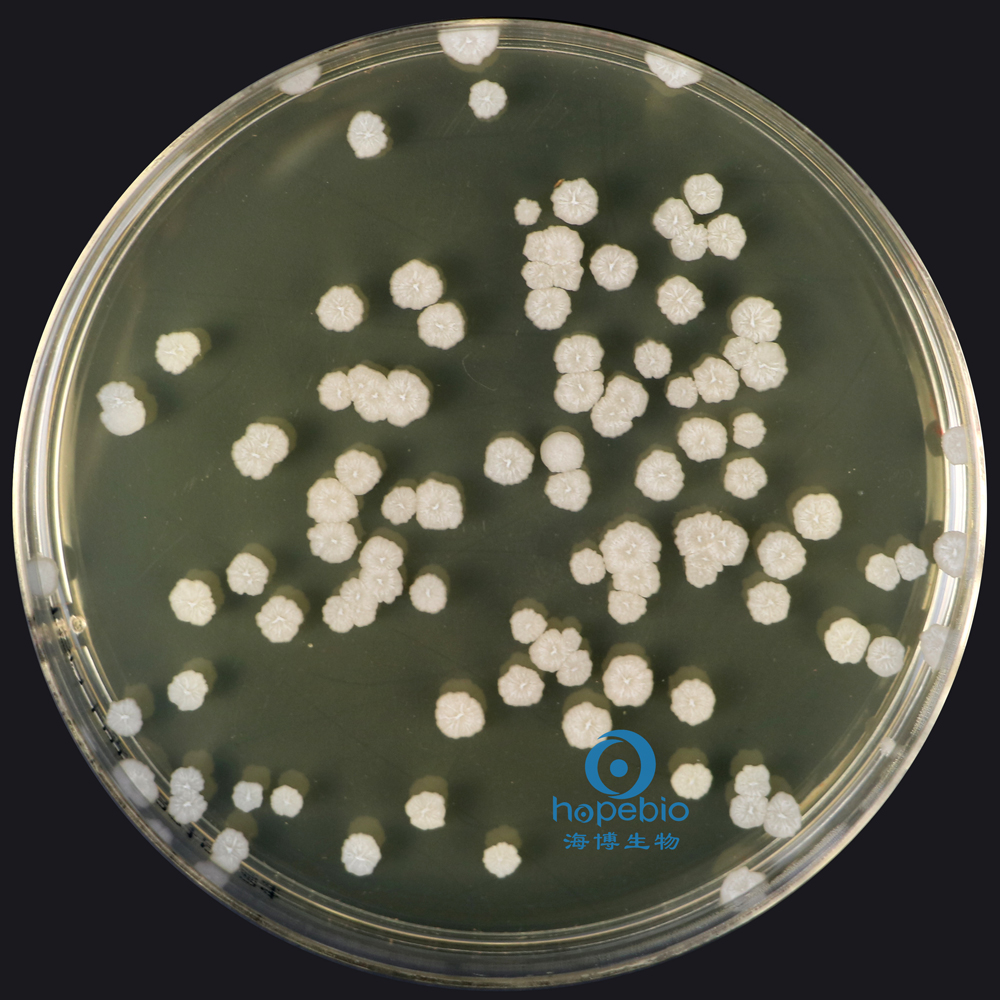
产品细节图片5

万千商家帮你免费找货
0 人在求购买到急需产品
- 详细信息
- 文献和实验
- 技术资料
- 英文名:
TSA Agar Granule
- 保质期:
3年
- 供应商:
青岛海博生物
- 规格:
250g
成分(g/L)
| 胰蛋白胨 | 15.0 |
| 大豆胨 | 5.0 |
| 氯化钠 | 5.0 |
| 琼脂 | 15.0 |
| pH值7.3±0.2 | 25℃ |
用法:称取本品 40.0g ,加热搅拌溶解于1000ml 蒸馏水中 ,分装三角瓶,121℃高压灭菌 15 分钟 备用。
不同细菌在胰蛋白胨大豆琼脂颗粒上的生长特征:
![]() |
![]() |
|||
| 金黄色葡萄球菌 有黄色色素 |
大肠埃希氏菌 无色透明大菌落 |
|||
![]() |
![]() |
|||
| 鼠伤寒沙门氏菌 无色大菌落 |
铜绿假单胞菌 有绿色色素 |
|||
![]() |
![]() |
|||
| 枯草芽孢杆菌 白色不规则菌落 |
白色念珠菌 白色菌落 |
|||
![]() |
||||
| 黑曲霉 白色菌丝 |
||||
胰酪大豆胨琼脂颗粒微生物灵敏度试验:
按标签用法制备培养基,接种以下质控菌株,放置30-35℃需氧培养18-24小时。
注:回收率计算时,用TSA琼脂做对照培养基。
风险提示:丁香通仅作为第三方平台,为商家信息发布提供平台空间。用户咨询产品时请注意保护个人信息及财产安全,合理判断,谨慎选购商品,商家和用户对交易行为负责。对于医疗器械类产品,请先查证核实企业经营资质和医疗器械产品注册证情况。
文献和实验培养的活检标本的唯一方法是将其置于-70摄氏度或液氮之中。 培养幽门螺杆菌的培养基包括非选择性及选择性两种。常用的非选择性培养基基础为脑心浸液琼脂、哥伦比亚琼脂、胰蛋白胨大豆琼脂以及Wilkins-Chalgren琼脂。培养基中需加7%-10%的去纤维蛋白马血。羊血、人血、马血清、氯化血红素、淀粉、胆固醇或环糊精(cyclodextrins) 也可代替马血。选择培养基则是在上述 培养基中添加一定的抗菌药物,如万古霉素、啶酸、二性霉素B、多粘菌素B以及甲氧苄氨嘧啶(TMP)。常用的有Skirrow
1. 引言 噬菌体展示是一项改造结合靶分子多肽的强大技术 [ 1 〜 3] 。蛋白质与噬菌体衣壳蛋白形成融合蛋白,可以在噬菌体表面表达,而相应的编码基因则包裹于噬菌体颗粒内 [4] 。包裹的 DNA 通过突变扩增构建噬菌体展示多肽库,为筛选各种变异体做准备。通过固定化靶分子体外结合实验,高亲和力的蛋白质可以从蛋白质展示库中筛选出来。随后,选定蛋白质的序列可以通过 DNA 测序推断出来。 靶蛋白可以通过构建噬菌粒载体与主要衣壳蛋白 [ 蛋白质-8 (P8) ] 或次要衣壳
作用的定向进化方面。例如,该方法在分离肽激素模拟物和人类 V-基因特异的抗体筛选中的应用。近来,噬菌斑展示技术通过在噬菌斑中展示底物和酶,可以用来选 择酶的不同催化活性。这种方法被 Jestin 和 Winter 成功用来富集有活性的聚合酶,通过在模板-引物双链体中加入有标签的核苷酸到噬菌体颗粒中 [18]。不久前 ,Romesberg 和他的合作者采用类似的方法对 Stoffel 基因进行了筛选 [19],筛选出的 Stoffel 某个片段整合 rNTP 的效率接近野生型的酶。 虽然遗传互补方法
技术资料暂无技术资料 索取技术资料